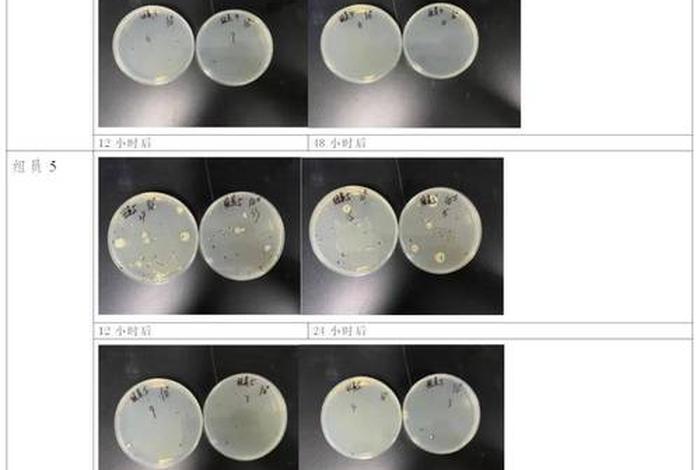
采集生活饮用水水质微生物检测样品时错误的操作是,微生物水样采集注意事项 采集生活饮用水水质微生物检测样品时错误的操作是,微生物水样采集注意事项

采集生活饮用水水质微生物检测样品时错误的操作是,微生物水样采集注意事项
-
采集,生活,饮用水,水质,微生物,检测,样品,时,

- 生活-自由百科知识生网
- 2025-12-03 16:11
- 自由百科知识网
采集生活饮用水水质微生物检测样品时错误的操作是,微生物水样采集注意事项 ,对于想学习百科知识的朋友们来说,采集生活饮用水水质微生物检测样品时错误的操作是,微生物水样采集注意事项是一个非常想了解的问题,下面小编就带领大家看看这个问题。
在探讨饮用水安全的过程中,水质微生物检测占据着举足轻重的地位。它如同是水质安全的“哨兵”,能够及时发现并预警潜在的健康风险。在采集生活饮用水水质微生物检测样品的过程中,难免会遇到一些误区和挑战。本文将带您深入探讨采集过程中的错误操作及注意事项,让您对这一看似简单实则重要的环节有更深入的理解。
一、错误的操作方式
1. 采样工具不洁:这是采集过程中的大忌。如果采样瓶、勺子等工具未经过严格的清洗和消毒,那么它们很可能会成为微生物污染的源头,使得样本的准确性大打折扣。
2. 采样时的不规范行为:包括未进行现场环境的清洁处理、未对采样人员进行必要的消毒措施等,这些都可能导致样本被外界微生物污染。
3. 样本保存不当:采集后的水样如果没有及时放入冷藏或冷冻环境中,或者保存容器不密封,都可能使样本在运输或保存过程中发生二次污染。
二、微生物水样采集的注意事项

1. 工具准备:
- 采样前需对所有工具进行彻底的清洗和消毒,确保无菌状态。
- 使用专用的采样瓶和密封盖,保证样本的密封性。
2. 采样环境与人员:
- 采样前需对采样地点进行清洁处理,避免外界微生物的干扰。
- 采样人员需进行必要的消毒措施,如穿戴防护服、戴口罩和手套等。
3. 正确采集:
- 选择具有代表性的水样点进行采集,确保能够真实反映整个水体的微生物状况。
- 使用无菌工具取样,确保取样过程中不引入其他杂质或微生物。
4. 样本保存与运输:
- 采集后的水样应立即放入冷藏或冷冻环境中,并确保密封性良好,防止二次污染。
- 运输过程中要避免长时间暴露在高温或阳光直射下,以免影响样本的稳定性。
5. 记录与标识:
- 对每个样本进行详细的记录,包括采样时间、地点、环境等信息。
- 使用清晰的标识标明样本的种类和状态,避免混淆。
生活饮用水水质微生物检测对于保障我们的饮水安全至关重要。只有严格遵循上述注意事项,我们才能确保采样的准确性,从而为饮用水安全提供可靠的数据支持。希望您能对微生物水样采集的重要性有更深入的了解,并能够在实践中加以运用。让我们一起努力,为保障饮用水安全贡献自己的一份力量!

以上是关于采集生活饮用水水质微生物检测样品时错误的操作是,微生物水样采集注意事项的介绍,希望对想学习百科知识的朋友们有所帮助。
本文标题:采集生活饮用水水质微生物检测样品时错误的操作是,微生物水样采集注意事项;本文链接:http://yszs.weipeng.cchttp://yszs.weipeng.cc/sh/642313.html。
猜你喜欢
- 采集生活饮用水汞参数样品时,应加哪种保存剂 - 采集水样的要求 2025-12-03
- 采集生活饮用水有哪些注意事项(生活饮用水采样时有哪些注意事项) 2025-12-03
- 采集生活饮用水有哪些注意事项、采集生活饮用水有哪些注意事项呢 2025-12-03
- 采集生活饮用水时高锰酸钾指数 - 生活饮用水高锰酸盐标准 2025-12-03
- 采集生活饮用水时,采样瓶应先用什么荡洗(生活饮用水采集注意事项) 2025-12-03
- 采集生活饮用水指定采样计划,采集生活饮用水指定采样计划怎么写 2025-12-03
- 采集生活饮用水中砷时用采样容器 饮用水的水样采集 2025-12-03
- 采集生活类小说、采集建造生存游戏小说 2025-12-03
- 采集生活物资、生活物资采购的规范与管理 2025-12-03
- 采集生活点滴教案 采集生活什么意思 2025-12-03














